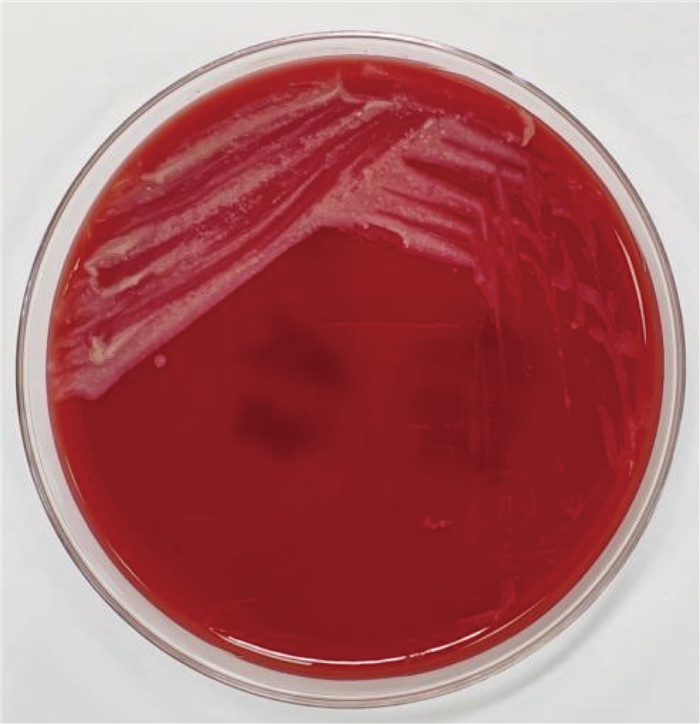
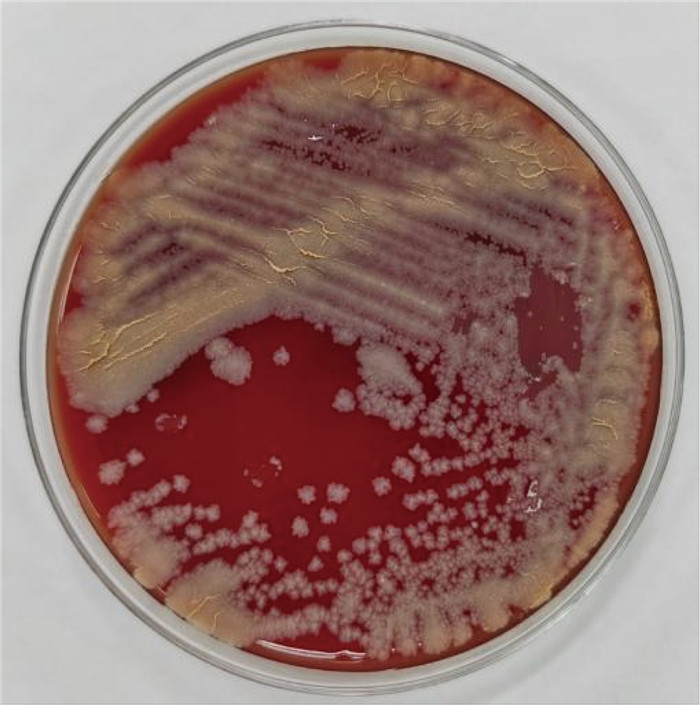

戈登菌属(Gordonia)是一种革兰氏阳性、需氧、过氧化氢酶阳性、氧化酶阴性、弱抗酸、无动力的细菌,该菌属属于放线菌纲、放线菌目、棒状杆菌亚目和戈登菌科,广泛分布于环境中,尤其是土壤中,是常见的奴卡菌样放线菌和环境微生物[1],但其在人类局部和全身性疾病中作为病原体被报道的很少,是极少见的导管相关性血流感染的病原菌。该菌属因具有轻微的耐酸性和不含芳基硫酸酯酶而区别于快速生长的分枝杆菌,又因具有还原硝酸盐的能力且不含菌丝而区别于诺卡氏菌属。戈登菌属感染的危险因素包括患者免疫功能低下和患有免疫抑制性疾病。戈登菌属大多引起免疫抑制患者的呼吸道感染,还可扩散至其他器官引起感染性疾病,包括中枢神经系统和软组织感染、心内膜炎以及外耳炎症、中耳炎、关节炎和菌血症[2]。既往病例报道中,大多数感染是由支气管戈登菌引起的,包括肺部疾病患者菌血症[3]、免疫抑制患者复发性胸腺脓肿[4]、冠状动脉搭桥术后患者的胸骨伤口感染[5]等。本文报告1例子宫内膜癌患者支气管戈登菌导管相关性血流感染的病例。
1 临床材料 1.1 病例资料患者,女性,41岁,子宫内膜癌ⅢA期术后接受放化疗中。入院查体结果如下:T:36.6 ℃,P:81次/min,R:18次/min,BP:94/60 mmHg, H:159 cm,W:52 kg,BSA:1.51 m3,KPS:90分。胸部计算机断层扫描(computed tomography,CT)平扫结果显示:双肺胸膜下区新发多发类结节或磨玻璃样密度小片影,形态不规则,右侧多,实性成分最大径约0.6 cm,形态及分布倾向血行播散性病变,患者胸膜新发结节考虑炎症可能性大。化疗第2日,患者诉乏力、头晕,无恶心呕吐、腹痛、腹泻等不适主诉,患者无明显诱因出现发热,最高39.3 ℃,予查血常规,退热处理,抽取静脉导管和外周静脉血培养。血常规+有核红细胞检测:白细胞计数(white blood cell count,WBC) 11.19×109/L,中性粒细胞百分比(neutrophilic granulocyte percentage,Neut%)95.4%,中性粒细胞绝对值(neutrophil absolute value,NEUT) 10.68×109/L,淋巴细胞百分比(lymphocyte percentage,LYM%)1.6%,淋巴细胞绝对值(lymphocyte absolute value,LYM) 0.18×109/L,血红蛋白(hemoglobin,Hb) 113 g/L,降钙素原(procalcitonin,PCT)0.395 ng/mL。患者炎症指标升高,淋巴细胞计数下降,血培养48 h,静脉导管血培养需氧瓶和外周静脉血培养需氧瓶报告阳性结果,考虑导管相关性血流感染,予注射用头孢哌酮舒巴坦钠3 g q12h抗感染治疗,同时予止吐补液对症支持治疗。患者化疗结束后出现Ⅲ度骨髓抑制伴发热,遂予白特喜升白治疗,血小板减少予口服利可君治疗,继续予注射用头孢哌酮舒巴坦钠抗感染治疗。一周后患者无发热,生命体征平稳,停用抗生素后出院。患者结束化疗后1月余门诊随访,一般状况良好,无发热,输液港港周无红肿,无压痛;胸部CT显示:原双肺胸膜下区多发类结节或磨玻璃样密度小片影已消失,右肺中叶少许索条影,考虑慢性炎症,余双肺未见明确结节及实变影;外阴阴道未见异常,阴道残端愈合良好,盆腔空虚未触及异常。
1.2 材料和方法 1.2.1 仪器与试剂BacT/ALERT 3D全自动血培养仪购于法国梅里埃BacT/ALERT 3D全自动血培养仪,配套使用血培养瓶,VITEK MS微生物质谱检测系统选自法国梅里埃,培养基使用英国Oxiod琼脂培养基,染色液来自珠海贝索Baso,镜检使用德国莱卡Leica DM3000生物显微镜。核酸抽提试剂盒、胶回收与聚合酶链式反应(polymerase chain reaction,PCR)产物纯化试剂盒由上海生工生物工程技术服务有限公司提供,PCR扩增试剂盒由上海翊圣生物科技有限公司提供。
1.2.2 方法使用法国梅里埃BacT/ALERT 3D全自动血培养仪对患者送检的静脉导管和外周静脉血进行全血细菌培养。全自动血培养仪阳性报警提示后,取患者报阳的血培养静脉导管血需氧培养瓶及外周静脉血需氧培养瓶,分别涂片进行革兰氏染色,染色干燥后进行显微镜下初步镜检。血培养静脉导管血需氧培养见革兰氏阳性杆状菌,外周静脉血需氧培养见革兰氏阳性杆状菌,患者有发热症状,炎症指标高,考虑为导管相关性血流感染。同时立即取患者报阳的血培养静脉导管血需氧培养瓶及外周静脉血需氧培养瓶培养液,接种于血琼脂培养基、巧克力琼脂培养基、麦康凯琼脂培养基,将接种培养液的琼脂培养基置于35 ℃培养箱进行培养,分别于培养24 h和48 h后观察菌落的生长状态,待菌落生长良好时对培养物进行抗酸染色、弱抗酸染色检查,同时进行基质辅助解吸/电离飞行时间质谱法(matrix-assisted laser desorption ionization time-of-flight mass spectrometry,MALDI-TOF MS)鉴定分析及16S rRNA基因扩增测序,并采用微量肉汤稀释法对纯培养物进行抗菌药物敏感性试验。
2 结果 2.1 菌落形态及镜下形态分别采集患者外周静脉血、静脉导管血液注入需氧瓶,行全自动血培养监测,于48 h后报阳性结果,立即接种并置于35 ℃培养箱,培养24 h后,在血琼脂培养基上见不溶血白色粗糙干燥菌落生长;培养至48 h,白色粗糙干燥菌落转变为橘黄色粗糙干燥菌落(见图 1、图 2)。挑取单个菌落进行涂片、革兰氏染色,镜下见革兰氏阳性杆菌(见图 3)。再进行弱抗酸染色,见少量细菌弱抗酸染色为弱抗酸阳性杆状菌(见图 4)。
|
| 图 1 血琼脂培养基35 ℃培养24 h的菌落形态 Fig. 1 Morphology of colony cultured at 35 ℃ for 24 h in blood agar medium |
|
| 图 2 血琼脂培养基35 ℃培养48 h的菌落形态 Fig. 2 Morphology of colony cultured at 35 ℃ for 48 h in blood agar medium |

|
| 图 3 分离菌株革兰氏染色油镜下形态 Fig. 3 The morphology of the isolated strain under oil microscope |

|
| 图 4 分离菌株弱抗酸染色油镜下形态 Fig. 4 The morphology of the isolated strains under oil microscope with weak acid-fast staining |
采用法国梅里埃VITEK MS微生物质谱检测系统对全血细菌纯培养物进行生物质谱鉴定分析,利用RUO数据库进行结果数据比对,鉴定此菌株为支气管戈登菌,置信度为93.0%,分析鉴定结果比对如图 5所示。

|
| 图 5 微生物质谱检测系统RUO数据库分析结果比对 Fig. 5 Comparison of database analysis results of microbial mass spectrometry detection system with RUO database |
根据EZUP柱式细菌基因组核酸抽提试剂盒的操作步骤提取该分离株核酸,使用16S rRNA基因的通用引物27F:5′-AGAGTTTGATCMTGGCTCAG-3’和1492R:5′-GGTTACCTTGTTACGACTT-3’,引物由上海生工生物工程技术服务有限公司(上海Sangon Biotech)合成。PCR反应体系:PCR缓冲液(10×)2.5 μL,MgCl2 (25 mmol/L) 2 μL,dNTP (2 mmol/L) 0.5 μL,引物27F、引物1492R各1.0 μL,Taq DNA Polymerase (5 U/μL) 0.5 μL,模板核酸1.0 μL,加入去离子水至25 μL。扩增条件:预变性95 ℃ 4 mim;循环95 ℃ 20 s, 58 ℃ 20 s, 72 ℃ 1.5 min,共35个循环;延伸72 ℃ 10 min。
通过DNA琼脂糖切胶纯化PCR扩增产物,回收目的片段后测序,测序结果用GenBank BLAST软件进行同源性分析。PCR扩增16S rRNA的测序结果与支气管戈登菌FDAARGOS_676的相似性为99.88%(见图 6)。系统进化树结果表明,目标菌株属于戈登菌属,与支气管戈登菌亲缘关系最接近(见图 7)。

|
| 图 6 分离株16S rRNA基因序列比对分析 Fig. 6 Comparison and analysis of 16S rRNA gene sequences of the isolates |

|
| 图 7 系统进化树 Fig. 7 Distance tree |
参照诺卡菌和其他需氧放线菌的药敏试验方法进行药敏试验,抗菌药物敏感性结果判读参照美国临床和实验室标准协会(Clinical and Laboratory Standards Institute)指南的微量肉汤稀释法折点[6]。结果表明,该菌对万古霉素、头孢曲松、头孢吡肟、环丙沙星、亚胺培南、美洛培南、利奈唑胺、复方新诺明敏感,具体药敏试验结果如表 1所示。
| Antimicro bialagent | Interpretive categories and MIC breakpoints (μg/mL) | MIC(μg/mL) | Sensibility | ||
| S | I | R | |||
| Imipenem | ≤4 | 8~16 | ≥32 | 0.032 | S |
| Meropenem | ≤4 | 8~16 | ≥32 | 0.25 | S |
| Linezolid | ≤8 | 16 | ≥32 | 0.5 | S |
| Vancomycin | ≤2 | 4~8 | ≥16 | 0.75 | S |
| Ceftriaxone | ≤8 | 16~32 | ≥64 | 1 | S |
| Cefepime | ≤8 | 16 | ≥32 | 1 | S |
| Ciprofloxacin | ≤1 | 2 | ≥4 | 1 | S |
| Trimethoprim-sulfamethoxazole | ≤2/38 | — | ≥4/76 | 0.5/9.5 | S |
| S: susceptible; I: intermediate; R: resistant; —: The break point has not been established. | |||||
戈登菌属Gordonia(曾命名为Gordona)于1971年首次在空洞性肺病患者和支气管扩张症患者的痰液中被分离出来,并因其生物学特性的不同,戈登菌属从其他需氧放线菌中独立出来成为新的菌属[7]。戈登菌在带有胶帽和石蜡棉塞的容器中培养时,其菌落形态看起来与结核杆菌类似,常规生化鉴定方法经常将其错误地鉴定为其他放线菌或分枝杆菌,而使用16S rRNA测序则能够显著提高其生物学鉴定的准确性。最近几年,不断有戈登菌属感染人类的相关报道,G. sputi、G. bronchialis和Gordonia terrae是Gordonia属的主要病原体[8]。戈登菌因能够形成一种名称为gordonan的生物膜而闻名,gordonan是一种酸性多糖,可诱导细胞聚集,增强细菌致病性和引起菌血症的能力[9]。戈登菌感染易发生在有留置装置(如中央静脉导管、腹膜透析导管和心脏装置)的患者中,大多数发生在有潜在恶性肿瘤或其他免疫功能低下的患者中[10]。Lo等[11]对1946年—2022年2月发表的所有关于戈登菌引起人类感染的英文报道进行了全面的文献综述,纳入的病例报告主要涉及亚洲(38%)和北美(37%)的医疗机构,在报告的临床风险因素中,31.5%的患者有中心静脉导管或血液透析置管,20.7%的患者正在接受腹膜透析治疗,约25%的患者免疫力低下,包括接受化疗的血液恶性肿瘤(15.2%)、接受化疗的实体瘤(7.6%)以及实体器官或骨髓移植(5.4%),其他风险因素包括心脏手术术后状态(9.0%)和糖尿病(7.6%);最常报告的戈登菌属相关感染是菌血症或导管相关性血流感染(35.9%)、腹膜透析相关腹膜炎(15.2%)和皮肤、软组织感染(12.0%)。
本案例分离到的支气管戈登菌是戈登菌的模式种,是一种从多种人体组织中分离出来的人类致病性微生物[12]。既往报道中,支气管戈登菌感染可发生于手术造成的胸骨伤口感染、冠状动脉搭桥术后、中央静脉导管的应用等。戈登菌属抗酸性较结核杆菌弱,呈短杆状,没有菌丝体形成,28~37 ℃培养可见橘黄色粗糙菌落,以支气管戈登菌最为典型。在以往的报道中,支气管戈登菌对抗菌药物普遍敏感[10, 13],如阿莫西林-克拉维酸、阿米卡星、头孢曲松、环丙沙星、利奈唑胺、米诺环素、复方星诺明、替加环素、万古霉素、甲氧苄啶等。本案例中分离出的支气管戈登菌亦对抗菌药物普遍敏感,与既往报道一致。在治疗戈登菌引起的感染时,初始治疗可使用碳青霉烯类或氟喹诺酮类药物,或联合使用氨基糖苷类药物[14],多种抗生素对支气管戈登菌有效,包括β-内酰胺类、碳青霉烯类、四环素类、氟喹诺酮类和磺胺类药物[15]。
戈登菌是一种罕见的条件致病菌,能够引起广泛的感染性疾病,特别是使癌症患者衰弱的败血症。本案例中,患者因子宫内膜癌术后化疗而免疫功能低下,进而引起由支气管戈登菌导致的导管相关性血流感染,经抗生素治疗预后良好。相关报道显示,革兰氏阳性杆菌的血液培养常常被忽视为潜在的类白喉污染物[16],且因缺乏精确的诊断途径,潜伏期长达3~4天,实验室常规培养及鉴定方法不能准确鉴定这些病原体,须使用其他方法(如基因测序或基质辅助解吸/电离飞行时间质谱法)鉴定[17-18]。能够从其他类似菌属中快速准确分离出致病细菌对于治疗至关重要,并且及时、合理地使用抗生素,能够为患者带来更有效、及时的治疗,提高了患者生存率。但目前为止,尚无针对戈登菌属感染的抗生素治疗指南,未来有必要开展进一步的多中心研究,以确定该病菌的抗生素图谱,并制定相关治疗指南,从而为临床提供可靠的治疗依据。
| [1] |
Arenskötter M, Bröker D, Steinbüchel A. Biology of the metabolically diverse genus Gordonia[J]. Appl Environ Microbiol, 2004, 70(6): 3195-3204.
[DOI]
|
| [2] |
Andalibi F, Fatahi-Bafghi M. Gordonia: isolation and identification in clinical samples and role in biotechnology[J]. Folia Microbiol (Praha), 2017, 62(3): 245-252.
[DOI]
|
| [3] |
Sng LH, Koh TH, Toney SR, Floyd M, Butler WR, Tan BH. Bacteremia caused by Gordonia bronchialis in a patient with sequestrated lung[J]. J Clin Microbiol, 2004, 42: 2870-2871.
[DOI]
|
| [4] |
Werno AM, Anderson TP, Chambers ST, Laird HM, Murdoch DR. Recurrent breast abscess caused by Gordonia bronchialis in an immunocompetent patient[J]. J Clin Microbiol, 2005, 43: 3009-3010.
[DOI]
|
| [5] |
Richet HM, Craven PC, Brown JM, Lasker BA, Cox CD, McNeil MM, Tice AD, Jarvis WR, Tablan OC. A cluster of Rhodococcus (Gordona) bronchialis sternal-wound infections after coronary-artery bypass surgery[J]. N Engl J Med, 1991, 324: 104-109.
[DOI]
|
| [6] |
Clinical and Laboratory Standards Institute. Susceptibility testing of mycobacteria, Nocardia spp., and other aerobic actinomycetes, 3rd ed[S]. Wayne: Clinical and Laboratory Standards Institute, 2018.
|
| [7] |
Tsukamura M. Proposal of a new genus, Gordona, for slightly acid-fast organisms occurring in sputa of patients with pulmonary disease and in soil[J]. J Gen Microbiol, 1971, 68(1): 15-26.
[DOI]
|
| [8] |
Herat HM, Athukoralage PS, Jamie JF. Two oleanane triterpenoids from gordonia ceylanica and their conversions to taraxarane triterpenoids[J]. Phytochemistry, 2000, 54(8): 823-827.
[DOI]
|
| [9] |
Kondo T, Yamamoto D, Yokota A, Suzuki A, Nagasawa H, Sakuda S. Gordonan, an acidic polysaccharide with cell aggregation-inducing activity in insect BM-N4 cells, produced by Gordonia sp[J]. Biosci Biotechnol Biochem, 2000, 64(11): 2388-2394.
[DOI]
|
| [10] |
Johnson JA, Onderdonk AB, Cosimi LA, Yawetz S, Lasker BA, Bolcen SJ, Brown JM, Marty FM. Gordonia bronchialis bacteremia and pleural infection: case report and review of the literature[J]. J Clin Microbiol, 2011, 49(4): 1662-1666.
[DOI]
|
| [11] |
Lo CK, Broderick C, Stefanovic A, Connors W, Murray M. Gordonia sputi-associated bloodstream infection in a renal transplant patient with chronic indwelling central venous catheter: a case report and literature review[J]. Access Microbiol, 2023, 5(6): acmi000560.v3.
[DOI]
|
| [12] |
Ivanova N, Sikorski J, Jando M, Lapidus A, Nolan M, Lucas S, Del Rio TG, Tice H, Copeland A, Cheng JF, Chen F, Bruce D, Goodwin L, Pitluck S, Mavromatis K, Ovchinnikova G, Pati A, Chen A, Palaniappan K, Land M, Hauser L, Chang YJ, Jeffries CD, Chain P, Saunders E, Han C, Detter JC, Brettin T, Rohde M, Göker M, Bristow J, Eisen JA, Markowitz V, Hugenholtz P, Klenk HP, Kyrpides NC. Complete genome sequence of Gordonia bronchialis type strain (3410)[J]. Stand Genomic Sci, 2010, 2(1): 19-28.
[DOI]
|
| [13] |
Moser BD, Pellegrini GJ, Lasker BA, Brown JM. Pattern of antimicrobial susceptibility obtained from blood isolates of a rare but emerging human pathogen, Gordonia polyisoprenivorans[J]. Antimicrob Agents Chemother, 2012, 56: 4991-4993.
[DOI]
|
| [14] |
Kim R, Reboli A. Other coryneform bacteria, Arcanobacterium haemolyticum, and rhodococci[M]// GL Mandell, JE Bennett, R Dolin. Mandell, Douglas, and Bennett's Principles and Practice of Infectious Diseases. Amsterdam, Netherlands: Elsevier, Inc, 2020: 2532-2542.
|
| [15] |
Blaschke AJ, Bender J, Byington CL, Korgenski K, Daly J, Petti CA, Pavia AT, Ampofo K. Gordonia species: emerging pathogens in pediatric patients that are identified by 16S ribosomal RNA gene sequencing[J]. Clin Infect Dis, 2007, 45(4): 483-486.
[DOI]
|
| [16] |
Alnajjar M, Mudawi D, Cherif H, Hashim SM, Zaqout A, Bougaila A, Jibril FI, Mohamed SF. Central catheter-related Gordonia bronchialis bacteremia in an immunocompromised patient: a case report, and literature review[J]. IDCases, 2023, 32: e01738.
[DOI]
|
| [17] |
Aoyama K, Kang Y, Yazawa K, Gonoi T, Kamei K, Mikami Y. Characterization of clinical isolates of Gordonia species in Japanese clinical samples during 1998-2008[J]. Mycopathologia, 2009, 168(4): 175-183.
[DOI]
|
| [18] |
Franczuk M, Klatt M, Filipczak D, Zabost A, Parniewski P, Kuthan R, Jakubowska L, Augustynowicz-Kopeć E. From NTM (Nontuberculous mycobacterium) to Gordonia bronchialis-A diagnostic challenge in the COPD patient[J]. Diagnostics (Basel), 2022, 12(2): 307.
[DOI]
|
 2024, Vol. 19
2024, Vol. 19


